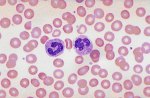

Face transplants are in the news from time to time, and we sometimes hear of the work of Professor Peter Butler in London. This is of some interest to me, not particularly from a medical point of view: transplanting a face I suspect involves craftsmanship similar to that needed by a restorer of ancient documents or paintings. The interest comes from the fact that when I was a Professor of Anatomy in Dublin I taught him, and employed him for a year. That is as near to fame as I’m likely to get. And there’s another source of fascination in this, and it’s to do with faces.
The squeamishness of the public concerning face transplants, and the moral questions that arise, reflect that fact that the face is what defines a person, even a personality for some people. The word person comes from persona, mask, which seems to imply that we all put on a mask to cover up our true selves. Is this also the sin of Adam? The face houses the organs of smell, taste, sight, and the most touch-sensitive parts of the body. The organs of hearing are not far away. The face is in a quadruped (and as apes we are just modified quadrupeds) the first part of the body to go into a new environment. It is the part of the body that confronts, as we heard in Isaiah: ‘I gave my cheeks to those who pulled out the beard; I did not hide my face from insult and spitting.’ The muscles of the face are called mimetic muscles because they mimic our emotions, communicating them to the observer. The brain connexions of the nerves that supply these facial muscles are specially protected from disease. I could go on: let’s just say that the face is of peculiar interest to me. And not just to me, it seems, but also to Holy Scripture.
The word face appears 25 times in Genesis alone. The Lord setting his face towards, or against, or hiding his face, or showing his face to someone or other. In the Gospels, Jesus comes down from the transfiguration mountain with a shining face. Think how the face is radiant in people who are doing exactly what they are put on the earth to do: shining with joy. Look at a photograph of the newly ordained (but hurry up before the radiance is wiped off their faces by the realities of ministry). Then a few pages later, Jesus sets his face to go to Jerusalem. Not joy this time, but gritted determination. Indeed, he sets his face like flint—which is the phrase used in tonight’s OT lesson: ‘The Lord God helps me; therefore I have not been disgraced; therefore I have set my face like flint, and I know that I shall not be put to shame.’
We see with our eyes and our eyes are watered by tears. The psalmist’s tears wetting his couch in his hours of distress, crying in the daytime. But tears of joy too. Tears that cleanse our faces. Tears in that most beautiful of Andersen’s stories, and one full of religious allegory, that melt the heart of ice that the Snow Queen has wrought in Kay. Tears of love that alone enable the ice blocks to spell the word eternity and allow Kay and Gerda to enter together. Eternity, here and now, out of time. The love that gives its all for me, as will I for my children.
The film Gandhi, when early in the film, Gandhi and Charlie Andrews on a crowded train, and Andrews invited up to the roof. A local says to him ‘I have friends who are Christian: they eat flesh and drink blood every Sunday.’ It’s meant to be a friendly greeting! In today’s culture of flesh-eating zombie films and vampire films and video games, Christianity has a hard time getting through to the unchurched used only to these ghoulish images of flesh and blood. And I have a confession to make: I would be ashamed to tell you how very recently it was that the penny dropped about the real significance of blood in Christian theology, and the reason for this is that I looked on blood from a medical point of view, whereas the key to the issue is in the layman’s point of view.
Picture someone attacked in the street, lying bleeding in the gutter. As the blood seeps away, so does the life-force. Lack of blood equals death, so blood equals life. For Jews and Muslims, ritual preparation of meat to eat involves draining all the blood so that they are not guilty of consuming the God-given ‘life force’. The blood that marks the doorposts in the first Passover (Exodus) signifies that the house will be preserved: blood equals life. And so the blood of Jesus, the blood that flows from his crucified side gives life to the world. All the references to blood of Jesus in Holy Scripture and in many rather gruesome hymns refer to the giving of life. The sacrifice on the cross is life giving for exactly this reason.
Some parallels can be drawn between the blood that circulates in our vessels and the blood of Jesus.
- Blood brings nutrient to the cells of the body. What more nutritious than the Sermon on the Mount, the two great commandments, the parables?
- Blood contains red cells that bring oxygen to the tissues. Jesus brings us the clear air of life. Get rid of the smoke of duty and oughts and shoulds, and instead take up the clear air of freedom from following the crowd. We are in the world, but not of the world.
- Blood contains white cells that fight disease and maintain health. Isn’t that exactly what the teachings and example of Jesus can do for us.
- Blood removes rubbish from the tissues of the body, and contains platelets that plug holes in the blood vessels. The resources of the Christian church are there for us when we feel burdened, and life overcomes us. Come unto me all that labour and are heavy laden, and I will refresh you.
So now when I hear of the ‘blood of the lamb’, I understand it as, quite simply, the will to do the Divine. As St John’s Gospel has it: ‘Unless you eat my flesh and drink my blood, you shall not have life within you’ (John 6:53).